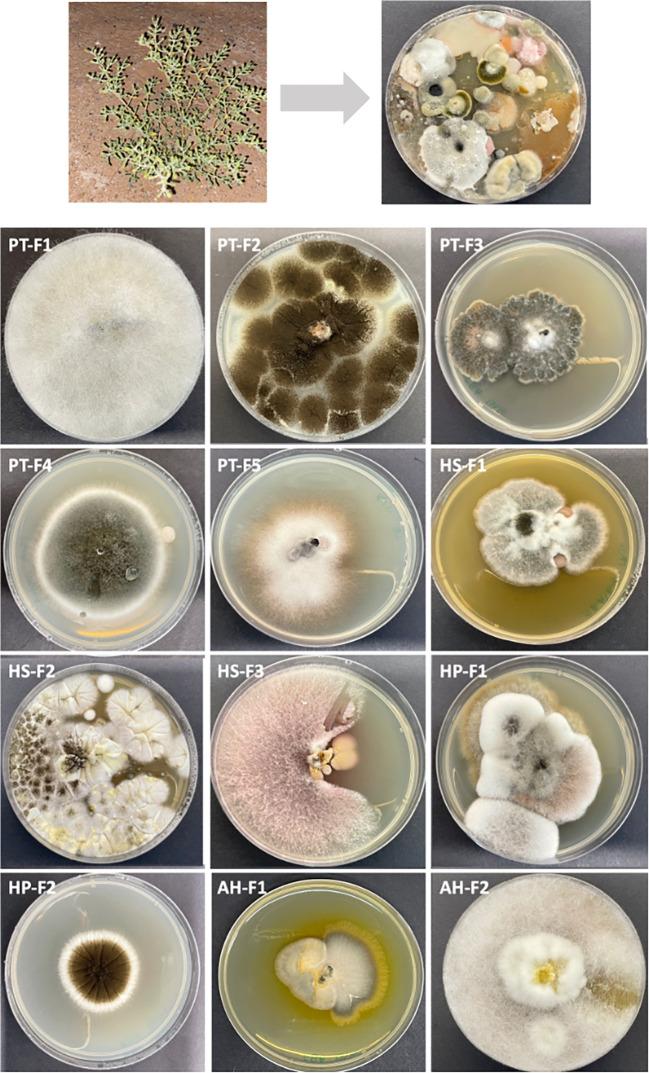
https://cdn.ncbi.nlm.nih.gov/pmc/blobs/6b3f/11914873/028875650e16/f1000research-13-173683-g0000.jpg

揭示来自阿拉伯半岛沙漠的可培养真菌微生物群落,其代表了药物发现和生物技术中生物化学物质的独特来源。
Revealing culturable fungal microbiome communities from the Arabian Peninsula desert representing a unique source of biochemicals for drug discovery and biotechnology.
作者信息
Mousa Walaa, Alramadan Najwa, Ghemrawi Rose, Abu Izneid Tareq
机构信息
College of Pharmacy, Mansoura University, Mansoura, 35516, Egypt.
College of Pharmacy, Al Ain University, Al Ain, Abu Dhabi, 64141, United Arab Emirates.
出版信息
F1000Res. 2024 Dec 17;13:1527. doi: 10.12688/f1000research.158130.1. eCollection 2024.
BACKGROUND
Microbes living at extremes evolve unique survival strategies to adapt to challenging environmental conditions. Among these strategies is their distinctive metabolic potential and ability to produce specialized metabolites enabling them to compete for limited resources and defend against predators. These metabolites have significant potential in pharmaceutical and industrial applications, particularly in the development of drugs and biochemicals.
OBJECTIVES
This study aimed to investigate the culturable fungal communities associated with four desert plants and their surrounding soils in the Arabian Peninsula desert to identify their bioactive properties.
METHODS
A total of 12 distinct fungal species were isolated from the plants and soils. Each plant hosted a unique set of fungi, demonstrating the diversity of desert-adapted fungal communities. Biological activities of the fungal extracts were evaluated through various assays, including antimicrobial, antifungal, anticancer, and antioxidant properties.
RESULTS
harbors the most diverse fungal community, dominated by genera such as , , , , and species comprise 33% of the total isolates, followed by at 16%. All extracts exhibit diverse activities, with species demonstrating the highest antioxidant activities and total phenolic and flavonoid content. Fungi from , particularly sp., sp., and sp., display potent activity against , while sp., sp., and sp. exhibit moderate inhibition against
CONCLUSION
This study highlights the importance of exploring extremophilic microorganisms, such as those found in desert ecosystems, as they offer a wealth of compounds that could address current challenges in drug discovery and biotechnology.
背景
生活在极端环境中的微生物进化出独特的生存策略以适应具有挑战性的环境条件。这些策略包括其独特的代谢潜力和产生特殊代谢产物的能力,使它们能够竞争有限的资源并抵御捕食者。这些代谢产物在制药和工业应用中具有巨大潜力,特别是在药物和生物化学制品的开发中。
目的
本研究旨在调查阿拉伯半岛沙漠中与四种沙漠植物及其周围土壤相关的可培养真菌群落,以确定它们的生物活性特性。
方法
从植物和土壤中总共分离出12种不同的真菌物种。每种植物都有一组独特的真菌,这表明了适应沙漠环境的真菌群落的多样性。通过各种测定方法评估真菌提取物的生物活性,包括抗菌、抗真菌、抗癌和抗氧化特性。
结果
拥有最多样化的真菌群落,主要由 、 、 、 和 等属主导, 物种占总分离物的33%,其次是 ,占16%。所有提取物都表现出不同的活性, 物种表现出最高的抗氧化活性以及总酚和黄酮含量。来自 的真菌,特别是 属、 属和 属,对 显示出强效活性,而 属、 属和 属对 表现出中等抑制作用。
结论
本研究强调了探索极端微生物的重要性,例如在沙漠生态系统中发现的那些微生物,因为它们提供了丰富的化合物,可应对当前药物发现和生物技术中的挑战。